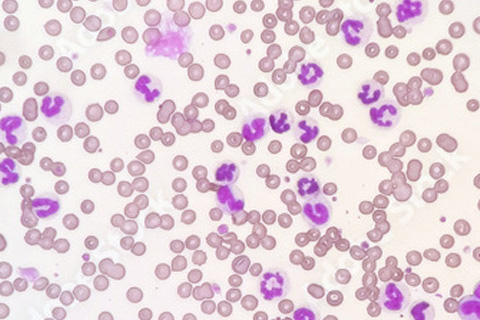
Research Interest 3

Research overview
More than 40 years of expertise
Our Research Expertise
Our teams brings together over 40 years of combined research experience, initially at the University of Zurich and ETH Zurich, and now continuing in our own facility (www.pathovet.ch). We focus on host-pathogen interactions, disease mechanisms, diagnostic tools, and translational research that informs both veterinary practice and collaborative scientific projects.
From Tiny Larvae to Giant Mammals
Our research spans a wide range of organisms, from the smallest model organisms to the largest mammals We study 5 mm fish larvae, sharp-snout sea bream, and transgenic zebrafish, which can be fully imaged under the microscope, as well as rats and transgenic mice, domestic animals and even 3.5-ton elephants, where tissue samples are collected during necropsy to investigate disease processes.
This spectrum reflects our commitment to understanding various veterinary diseases, while integrating practical veterinary perspectives.
Our Research Areas
We investigate:
- Iron regulation and metabolism
- Marine intracellular bacteria affecting fish welfare
- Oxygen dynamics and exercise in cancer
- Broader veterinary health topics
By combining molecular techniques with traditional histopathology in a comprehensive patholomic approach, we translate scientific findings into actionable knowledge. Our work demonstrates both technical competence and innovative capacity, providing a foundation for collaborations, research funding applications, and applied solutions in veterinary and biomedical science.
Our Research Projects

The Role of Iron in Health and Disease
You will soon discover more about these projects.
Marine Intracellular Bacteria
You will soon discover more about these projects.
Cancer Research
You will soon discover more about these projects.Our Services and Support
Diagnostics
With over 20 years of experience in veterinary medicine and pathology, we provide expert support in:
- Necropsy and post-mortem examinations for all animal species
- Histology and Cytology
- Specialized staining techniques, including immunofluorescence and immunohistochemistry
- Microscopy services, including brightfield and fluorescence microscopy, digital scanning, and online image sharing
- Quantitative and qualitative assessments of histological structures, cell types, depositions, and other tissue features
- Morphometric and stereological analyses for precise tissue and organ evaluation
- Consultation on sample collection, preservation, and processing to optimize downstream analyses
- Tailored diagnostic workflows designed to address specific research or clinical questions
Molecular Biology
With over 30 years of experience in molecular biology, biochemistry, and cell biology, we provide support in or direct execution of:
- PCR/qPCR assay design and development across all domains (bacteria, viruses, eukaryota)
- Sample isolation, preparation, and analysis from diverse biological materials
- Data analysis, interpretation, and reporting
- Fluorescence in situ hybridization (FISH)
- Consultation on experimental design and assay optimization for reliable, reproducible results
Scientific Consulting
With over 20 years of research experience, FELASA accreditation, more than 15 years as an animal study director, and over 10 years managing animal facilities, we provide consulting and assistance in:
- Experimental study design (in vitro and in vivo)
- Designing and reviewing animal experimental studies
- Preparation and support for animal license applications before submission to cantonal authorities
- Guidance on ethical, regulatory, and welfare considerations in animal research
Let Us Discuss Your Project
- Write us: welcome@pathovet.ch
- Call us: +41 (0)52 208 99 20
- Visit our facility: Buckstrasse 2, Tagelswangen in 8307 Effretikon.
Hinweis: Der Bereich “Forschung” auf unserer Internetseite ist nur auf Englisch verfügbar.
Note: The “Research” section on our website exists only in English.
